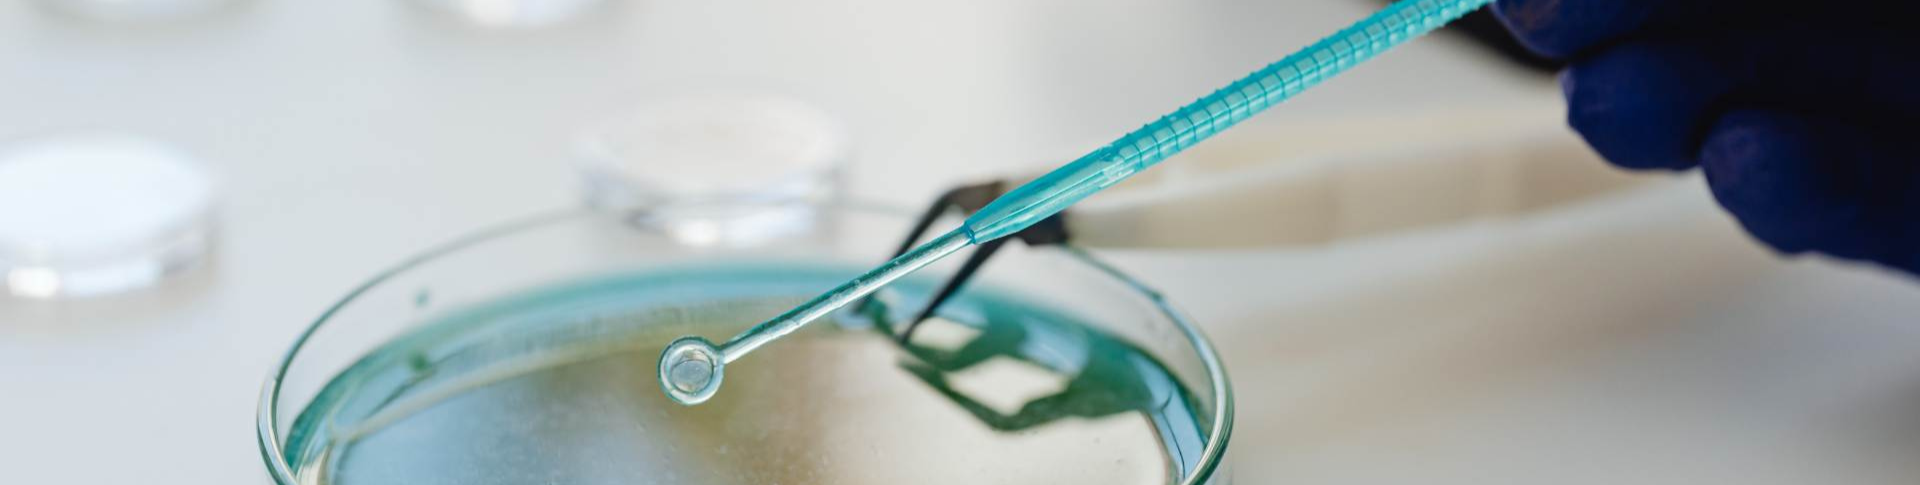
Microbiological Services (1)

Microbiological analyses are performed according to the current pharmacopoeias. Our services include:
- Determination of total aerobic microbial count and amount of yeast or mould (TAMC/TYMC)
- Testing for specified microbes
- Determination of preservative efficacy
- Validation of test methods and complete documentation
- Growth promotion testing of microbiological culture media
- Comprehensive testing of biological indicators, such as efficacy of sterilisation and spore testing
- Hygiene controls
- Microbiological assay of antibiotics.